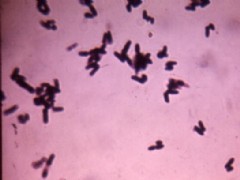
回歸熱
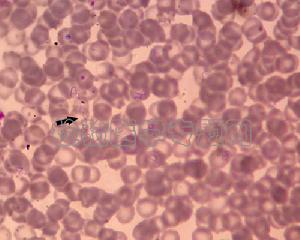
回歸熱

流行特徵
回歸熱螺鏇體(borreliarecurrentis)長約8~18μm,螺鏇數5~10個,一般由體虱(pediculushumanus)傳染,
 回歸熱螺鏇體
回歸熱螺鏇體 回歸熱
回歸熱人類對這兩種回歸熱均普遍易感。病後發生免疫,但二病無交叉免疫性。病原體分布於病人的血液及內臟中。在間歇期間,由於體內產生免疫球蛋白,使螺鏇體凝集以至消滅,症狀也消失,但仍有小量病原體潛伏在內臟中,逐漸繁殖可引起復發。復發數次後,產生了足夠的免疫力,全部螺鏇體被殺滅,症狀才不再出現。
偶有由輸血而發生感染,供血者當時雖無病徵,受血者經過1周左右可出現症狀。孕期患此病,可通過胎盤轉送病原體給胎兒,發生先天性回歸熱。
病原學
 回歸熱
回歸熱疾病病因
(一)傳染源:虱傳回歸熱的唯一傳染源是病人;蜱傳回歸熱的主要傳染源是鼠類,病人亦可為傳染源。
(二)傳播途徑:虱傳回歸熱的傳播以體虱和頭虱為傳播媒介。蜱傳回歸熱的傳播媒介為不同種類的軟蜱。蜱可終身攜帶螺鏇體。並可經卵傳代。故蜱不僅是傳播媒介,也是病原體的貯存宿主。
(三)易感人群:男女老幼均易感。病後免疫力不持久。兩型回歸熱之間無交叉免疫。
疾病檢查
多數患者白細胞總數增高,可達1.5~2×1010/L,中性粒細胞增加。
 回歸熱
回歸熱1.血小板及出凝血時間大多正常,但重症者可有異常。
2.血清丙氨酸轉氨酶常升高,血清膽紅素可增高。
3.尿中有少量蛋白、管型及紅、白細胞。
4.腦脊液壓力稍增,蛋白及淋巴細胞輕度增加。
反覆發熱應懷疑本病,在發熱期血液中發現螺鏇體即可確診。在暗視野檢查或經賴特或吉姆薩染色的薄血片或原血片檢查可找見螺鏇體(吖啶橙染色檢查血液或組織比周圍血液賴特或吉姆薩染色檢查更敏感)。由於蜱在晚上叮咬患者時間短暫而且無痛,故大多數病人無法提供蜱叮咬史,但可訴說在洞穴或農舍過夜的病史。蜱感測染時,將病人的血液注射到小鼠或大鼠的腹腔,在3~5天內從動物的尾部血液內可查見大量螺鏇體。鑑別診斷包括萊姆關節炎,瘧疾,登革熱,黃熱病,鉤端螺鏇體病,斑疹傷寒,流感和腸熱病。
發病原理與病理變化
回歸熱的發作和間歇與螺鏇體的增殖、抗原變異及機體的免疫反應有關。回歸熱螺鏇體侵入人體後在血液和內臟大量繁殖並產生多種代謝產物,引起發熱和中毒症狀。與此同時,機體逐漸產生特異性IgM和IgG抗體,可激活補體及吞噬細胞將螺鏇體大量溶解殺滅,臨床進入間歇期。但在肝、脾、腦、骨髓中殘留的螺鏇體,通過抗原性變異成為對抗體有抵抗力的變異株,這些螺鏇體繁殖到一定數量後再度入血引起第二次發熱(回歸)。如此反覆多次,直至機體產生足夠免疫力,螺鏇體被全部殺滅,疾病方痊癒。
螺鏇體產生的毒素及代謝產物,可破壞紅細胞引起溶血及貧血;並可損害毛細血管內皮細胞、血小板及誘發DIC而導致出血性皮疹和全身出血傾向。
病理變化以脾、肝、腎、腦和骨髓為主。脾臟明顯腫大,有散在性梗塞壞死及小膿腫,鏡檢可見巨噬細胞和漿細胞浸潤,單核—巨噬細胞增生。肝、心、腎可見充血、出血及灶性壞死。腦水腫、充血、腦膜有炎性浸潤。
疾病特點
回歸熱是一種特殊螺鏇體引起的急性傳染病。本病主要通過體虱及軟蜱傳染。由體虱傳染者,發病多在冬春季,
回歸熱
回歸熱回歸熱的臨床特徵是陣發性高熱,短期熱退後呈無熱間歇,數日後又反覆發熱,發作期與間歇期交替反覆出現,因此稱之為回歸熱。本病起病急驟,初起即表現為高熱,體溫可高達39℃~41℃,多呈稽留熱,亦可表現為弛張熱或間歇熱,常伴有寒戰。高熱的同時尚有頭痛、四肢肌肉及關節疼痛,皮膚乾熱,四肢及軀幹可見出血性皮疹。有的患兒可見黃疸、肝脾腫大、結膜充血等。高熱持續6~7天左右,體溫驟然下降,大量汗出,隨即轉入間歇期。在間歇期階段,其它症狀也隨之減退或消失。大約經過6~9天間歇後,再度高熱,其它症狀又隨之出現。再次發熱時症狀漸輕,發熱時間漸短,而間歇期延長。如此復發1~2次,有的可復發多次,逐漸好轉,恢復正常。
(一)虱傳型回歸熱
潛伏期2~14天,平均7~8天,起病大多急驟,始以畏寒、寒戰和劇烈頭痛,繼之高熱,體溫1~2天內達40℃以上,多呈稽留熱,少數為弛張熱或間歇熱。頭痛劇烈,四肢關節和全身肌肉酸痛。回歸發作多數症狀較輕,熱程較短,經過數天后又退熱進入第二個間歇期。一個周期平均約2周左右。以後再發作的發熱期漸短,而間歇期漸長,最後趨於自愈。
(二)蜱傳型回歸熱
潛伏期4~9天,臨床表現與虱傳型相似,但較輕,熱型不規則,復發次數較多,可達5~6次。蜱咬部位多呈紫紅色隆起的炎症反應,局部淋巴結腫大。肝脾腫大、黃疸、神經症狀均較虱傳型為少,但皮疹較多。
回歸熱在高熱時應給予物理降溫,並給予高熱量流質飲食,補充足量液體和電解質。在體溫驟降之時,應注意防止虛脫的發生。
臨床特點
疏螺鏇體屬微生物引起的急性傳染病。臨床特點為起病急驟﹑發熱﹑頭痛﹑全身肌肉及關節疼痛﹑肝脾腫大,嚴重者可有昏迷﹑譫妄﹑黃疸及出血傾向。發熱數日後進入間歇期,發熱期與間歇期交替出現,可復發多次,每次發作的時間逐漸縮短,病情逐漸減輕,故為自限性感染。根據傳播媒介的不同可分為虱傳回歸熱及蜱傳回歸熱兩類,前者流行於衛生條件差的地區,以冬春季為多,病人是唯一的傳染源,體虱是其主要媒介。病原體為回歸熱疏螺鏇體,又稱奧伯邁爾氏疏螺鏇體。蜱傳回歸熱散發於熱帶﹑亞熱帶,有嚴格的地區性,以春夏季節為多,鼠類是其主要傳染源,病人也是傳染源。蜱受染後,傳染性將持續終生,且能經卵傳代,故蜱既是傳宗媒介,也是傳染源。蜱的體腔﹑唾液及糞便內均有螺鏇體。病原體為蜱傳回歸熱螺鏇體,其種類很多,其中以達頓氏疏螺鏇體為代表。虱能傳播蜱傳螺鏇體,但蜱不能傳播虱傳回歸熱螺鏇體。人對兩型螺鏇體普遍易感,病後免疫力短暫,虱型者約持續2~6個月,蜱型者約為1年。兩型螺鏇體間無交叉免疫。預後取決於治療早晚﹑患者年齡﹑有無嚴重併發症等;及早套用抗生素可使病死率低於5%。嬰兒病死率可達20%以上,凡有深度黃疸﹑中樞神經系統症狀及明顯出血傾向者,病情嚴重,預後較差。
臨床表現
虱吸入病人血液後,病原體在其體腔中大量繁殖,但不進入唾腺,人搔癢時將虱壓碎,虱體腔內的螺鏇體通過人
 虱
虱蜱傳回歸熱發病常因蜱叮咬引起,蜱的成蟲﹑幼蟲叮咬吸血時,可將病原體直接注入人體,病原體也可隨抓癢傷口進入人體。病原體侵入局部有紫紅色炎症改變,中央隆起,抓破後易發生化膿感染,局部淋巴結腫大。一般症狀與虱型回歸熱相似,但病情較輕。
併發症
1、支氣管炎及肺炎為本病較常見的併發症,此外,腮腺炎、中耳炎、結膜炎等也非罕見。
2、瀰漫性血管內凝血(DIC)雖不多見,但當患者有出血傾向時應考慮到此合併症存在之可能性。若血小板減少同時第V因子活性減低,均預示可能發生瀰漫性血管內凝血。
3、本病恢復後很少殘留後遺症。個別患者可能遺留面肌麻痹、眼瞼下垂或偏癱失語等神經系統症狀。
治療方法
滅虱對控制回歸熱的流行很重要。
10%二二三(即DDT)液體為有效的滅虱殺蟲劑,包括頭髮的處理。如發現有體虱,應速將衣褲換下,在沸水中煮30分鐘,虱和虱卵均可殺死。對不宜煮沸的衣服,用10%二二三的滑石粉劑撒於衣褲內面,48小時可殺死體虱,效力可維持1個月左右。或將衣服放入1%~2%二二三乳劑中浸泡,然後曬乾,效力可維持6個月。被褥等也應同樣處理。這些衣物在穿用前套用熱水洗淨以避免殺蟲劑對患兒有毒性作用。敵敵畏(DDV)易使小兒中毒,以不用為好。預防蜱傳回歸熱,應著重滅鼠防蜱。根據中國統計,1979年以後全國再沒有發生虱傳回歸熱病例。
 虱
虱(二)病原治療:首選四環素族抗生素。
發熱期應臥床休息,給予高熱量飲食﹑足量水分及降溫,必要時用腎上腺皮質激素等對症治療。抗生素能消除體內螺鏇體,故治療有特效,四環素族抗生素是目前最有效的藥物,一般選用四環素,苄星青黴素﹑普魯卡因青黴素療效亦佳,國外報告頓服強力黴素100mg一次亦可獲良好效果。吸收緩慢的青黴素不能殺滅腦內的螺鏇體,故治療後疾病有復發可能;部分蜱傳回歸熱對青黴素不敏感,故不宜選用;抗生素治療中須嚴加注意可能出現嚴重的休克反應即雅里施-赫克斯海默二氏反應,重者可致死,這可能是螺鏇體大量溶解時出現的過敏性休克反應,故第一次抗生素劑量不宜太大,必要時可與腎上腺皮質激素合用。新胂凡納明只用於晚期反覆發作﹑對抗生素療效較差的蜱型回歸熱患者。
預後
早期套用抗生素效果較好,兒童預後良好,年老體弱孕婦預後較差,有嚴重併發症者預後險惡虱傳回歸熱病死率為2%~6%,大流行時可高達50%蜱傳回歸熱病死率為2%~5%,但新生兒病死率可高達60%。預防
預防預防虱型回歸熱,主要是及時治療病人及徹底滅虱。預防蜱型回歸熱,則必須防鼠﹑滅鼠﹑滅蜱及防止蜱類鑽進住處,可採用1~2%DDVP(敵敵畏)噴灑滅蟲,野外作業時採取防蜱滅蜱措施。
1.一般治療護理工作十分重要。對高熱、頭痛、貧血、脫水都應予適當的對症療法。對黃疸病例應先由靜脈點滴10%葡萄糖溶液,保護肝功能,然後進行小劑量的特效療法。
2.抗生素療法青黴素水劑劑量為3萬U/(kg·次),每日肌注4次,連續4日以上,總量約60萬U/kg或稍多,或肌注普魯卡因青黴素G30萬U,每日1次,連用10天。對高熱及黃疸病例,抗生素應從小量開始,慎防因病原體分解過速而引起雅、赫二氏不良反應(jarisch-Herxheimerreaction)。經過2~3次注射後一般症狀顯著減輕,約在24小時退熱,肝脾也於數日內縮小,大多不再復發。一般在發熱末期給特效治療時,退熱更快,這時因那時體內已漸生抗體,更易退熱。退熱時出汗過多,應有守護觀察,給以補液等對症處理,必要時用升壓藥物或適量皮質激素。紅黴素40mg/(kg·d),分3~4次口服,連服10天。亦有顯效。
相關詞條
參考連結
1 http://zhzyw.org/crb/hgr/
2 http://www.chinavalue.net/wiki/showcontent.aspx?titleid=30315
3 http://www.shoyao.com/Article/D/20061024/A817629D3AB01E41571F114AC33165DE.htm
4 http://www.dzjk.com/chinadoc/jibing.aspx?diseaseid=972
